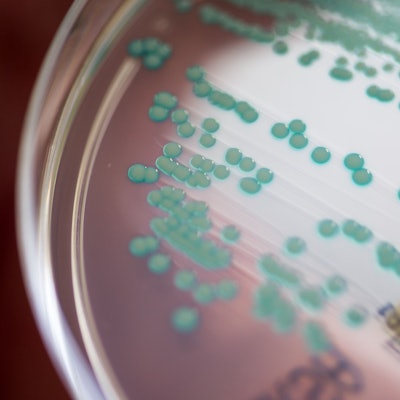
Eine Petrischale mit MRSA-Keimen

Die Chemikalie Bisphenol A kommt in zahllosen Alltagsprodukten vor - etwa in Lebensmittelverpackungen. Laut einer Studie haben 83 Prozent der Deutschen im Körper Konzentrationen oberhalb des Grenzwertes. Was bedeutet das?
Schädlicher StoffMehrheit der Deutschen hat zu viel BPA im Körper

Unbefüllte Plastikflaschen befinden sich in der Produktion eines Getränkeherstellers. Die Europäer sind neuen Forschungsdaten zufolge zu großen Mengen der gesundheitsschädlichen Chemikalie Bisphenol A (BPA) ausgesetzt.
Copyright: Sebastian Gollnow/dpa
83 Prozent der deutschen Bevölkerung sind der Chemikalie Bisphenol A (BPA) in Mengen ausgesetzt, die als gesundheitlich bedenklich gelten. Das geht aus Daten hervor, die die Europäische Umweltagentur (EEA) am Donnerstag vorstellte. Eine EU-Studie habe gezeigt, dass in drei der insgesamt elf untersuchten Länder wahrscheinlich sogar alle Teilnehmer BPA-Mengen oberhalb des als unbedenklich geltenden Grenzwertes aufwiesen. Das seien Frankreich, Portugal und Luxemburg.
Bisphenol A ist eine synthetische Chemikalie, die in vielen Produkten verwendet wird - darunter wiederverwendbare Wasserflaschen, Trinkwasserleitungen und Lebensmittelbehälter aus Kunststoff und Metall wie etwa Konservendosen. Laut Bundesinstitut für Risikobewertung (BfR) kommt SIE auch in Smartphones oder DVDs vor. Menschen nehmen die Substanz demnach hauptsächlich mit der Nahrung auf, aber auch Luft, Staub oder Wasser seien mögliche Quellen.
Belastung weit über dem Akzeptablen
Die Belastung der Bevölkerung liegt der EEA zufolge weit über akzeptablen Sicherheitswerten. Dies stelle ein potenzielles Gesundheitsrisiko für Millionen von Menschen dar, teilte die Agentur mit. Schon in geringen Mengen könne die Chemikalie das Immunsystem schwächen, zudem könne es zu verringerter Fruchtbarkeit und allergischen Hautreaktionen kommen.
Von den insgesamt 2756 Studienteilnehmern wiesen je nach Land 71 bis 100 Prozent der Untersuchten im Urin BPA-Mengen oberhalb des Grenzwertes auf. Die gemeldeten Werte seien Mindestwerte, es bestehe sogar die Möglichkeit, dass in allen elf Ländern, die an der Studie teilnahmen, 100 Prozent der Teilnehmer über den sicheren Grenzwerten lägen. Dies werfe erhebliche gesundheitliche Bedenken für die breitere EU-Bevölkerung auf.
Leena Ylä-Mononen, Direktorin der Umweltagentur mit Sitz in Kopenhagen, schrieb in einer Mitteilung: „Wir müssen die Ergebnisse dieser Forschung ernst nehmen und auf EU-Ebene mehr Maßnahmen ergreifen, um die Exposition gegenüber Chemikalien zu begrenzen, die ein Risiko für die Gesundheit der Europäer darstellen.“ BPA sei ein weitaus größeres Gesundheitsrisiko als bisher angenommen.
Die Mitteilung des EEA basiert auf Daten einer EU-Studie zum Human-Biomonitoring. Diese sammelte von Januar 2017 bis Juni 2022 europaweit Daten zur Belastung der Bevölkerung mit Chemikalien und den damit verbundenen Auswirkungen auf die Gesundheit.